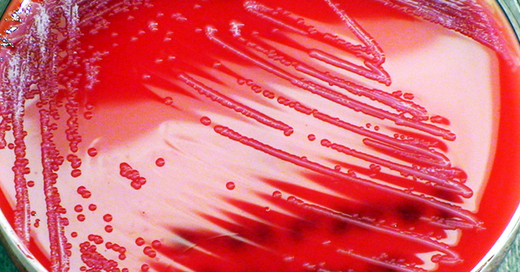

Tag Archiv: Baggersee
 25. Juni 2023
Interaktive Karte: Alle Badeseen und offenen Schwimmbäder in Südbaden
Hier können Sie entspannen und plantschen - trotz der heißen Temperaturen (…)
25. Juni 2023
Interaktive Karte: Alle Badeseen und offenen Schwimmbäder in Südbaden
Hier können Sie entspannen und plantschen - trotz der heißen Temperaturen (…)
 12. September 2022
Labor weist giftige Blaualgen im Wasser des Kleinen Opfinger Baggersees nach
Bereits in der letzten Woche hatten die Behörden nach dem ersten Verdachtsfall eine Warnung herausgegeben. (…)
12. September 2022
Labor weist giftige Blaualgen im Wasser des Kleinen Opfinger Baggersees nach
Bereits in der letzten Woche hatten die Behörden nach dem ersten Verdachtsfall eine Warnung herausgegeben. (…)
 06. September 2022
Behörden raten vom Schwimmen im Kleinen Opfinger Baggersee dringend ab
In dem See besteht aktuell der Verdacht auf gesundheitsschädliche Keime im Wasser. (…)
06. September 2022
Behörden raten vom Schwimmen im Kleinen Opfinger Baggersee dringend ab
In dem See besteht aktuell der Verdacht auf gesundheitsschädliche Keime im Wasser. (…)
 15. Juli 2022
Gemeinde spricht Badeverbot für Köndringer Baggersee aus
Das Gewässer ist großflächig mit Cyanobakterien befallen (…)
15. Juli 2022
Gemeinde spricht Badeverbot für Köndringer Baggersee aus
Das Gewässer ist großflächig mit Cyanobakterien befallen (…)
 20. Juni 2022
Badeunfall mit Kind in Reinach und Titisee, erfolglose Suche am Opfinger Baggersee
Der Bademeister musste einen 7 Jahre alten Jungen wiederbeleben, in Freiburg war ein Großaufgebot im Einsatz. (…)
20. Juni 2022
Badeunfall mit Kind in Reinach und Titisee, erfolglose Suche am Opfinger Baggersee
Der Bademeister musste einen 7 Jahre alten Jungen wiederbeleben, in Freiburg war ein Großaufgebot im Einsatz. (…)
 07. Juni 2022
Schwimmende Solaranlage auf dem Baggersee Niederrimsingen geplant
60 Prozent des produzierten Stroms sollen direkt im Kieswerk genutzt werden (…)
07. Juni 2022
Schwimmende Solaranlage auf dem Baggersee Niederrimsingen geplant
60 Prozent des produzierten Stroms sollen direkt im Kieswerk genutzt werden (…)
 07. Juni 2022
Jugendlicher ertrinkt in einem Baggersee in der Ortenau
Obwohl der 15-Jährige offenbar Nichtschwimmer war, soll er bei Meißenheim ins Wasser gestiegen sein. (…)
07. Juni 2022
Jugendlicher ertrinkt in einem Baggersee in der Ortenau
Obwohl der 15-Jährige offenbar Nichtschwimmer war, soll er bei Meißenheim ins Wasser gestiegen sein. (…)
 25. Juni 2021
Diese Tipps geben die Rettungsschwimmer der DLRG zur laufenden Baggersee-Saison
Damit die Abkühlung in den Badeseen nicht zur Katastrophe wird, sollten Badegäste verschiedene Dinge beachten. (…)
25. Juni 2021
Diese Tipps geben die Rettungsschwimmer der DLRG zur laufenden Baggersee-Saison
Damit die Abkühlung in den Badeseen nicht zur Katastrophe wird, sollten Badegäste verschiedene Dinge beachten. (…)
 21. Juni 2021
26-Jähriger bei Badeunfall in Waldsee bei Willstätt-Hesselhurst ertrunken
Der junge Mann war beim gemeinsamen Schwimmen mit Freunden plötzlich untergegangen und nicht mehr aufgetaucht. (…)
21. Juni 2021
26-Jähriger bei Badeunfall in Waldsee bei Willstätt-Hesselhurst ertrunken
Der junge Mann war beim gemeinsamen Schwimmen mit Freunden plötzlich untergegangen und nicht mehr aufgetaucht. (…)
 17. Juni 2021
Suche nach vermisstem Schwimmer im Schutterwälder Baggersee beendet – Mann kann nur noch tot geborgen werden
Helikopter, Drohne und Rettungstaucher waren seit Mittwochabend im Einsatz (…)
17. Juni 2021
Suche nach vermisstem Schwimmer im Schutterwälder Baggersee beendet – Mann kann nur noch tot geborgen werden
Helikopter, Drohne und Rettungstaucher waren seit Mittwochabend im Einsatz (…)
 17. September 2020
Baden im kleinen Opfinger Baggersee ab sofort wieder möglich
Warnschilder, die vom Baden abraten, werden entfernt (…)
17. September 2020
Baden im kleinen Opfinger Baggersee ab sofort wieder möglich
Warnschilder, die vom Baden abraten, werden entfernt (…)
04. September 2020
Baden im kleinen Opfinger Baggersee untersagt
Im Gesamtbereich des Sees wurden Enterokokken im Wasser vorgefunden (…)
04. September 2020
Baden im kleinen Opfinger Baggersee untersagt
Im Gesamtbereich des Sees wurden Enterokokken im Wasser vorgefunden (…)